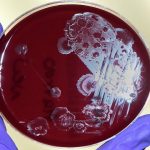
Clostridioides difficile, buone speranze dal trattamento con un lievito modificato

Sviluppato da un team di Singapore-MIT Alliance for Research and Technology (SMART), è più rapido, efficiente ed economico.
Un nuovo modo per produrre globuli rossi umani tramite colture in laboratorio è stato sviluppato da un team di Singapore-MIT Alliance for Research and Technology (SMART). Secondo quanto riferisce il relativo comunicato stampa, questo nuovo metodo rende il tempo di coltura molto più breve, dimezzandolo addirittura, grazie a nuovi metodi per la purificazione, più precisi e meno dispendiosi. Il processo stesso di purificazione dei globuli rossi prodotti laboratorio rappresenta di per sé una fase essenziale e importante.
Questi globuli rossi potrebbero naturalmente servire per le trasfusioni di sangue, pratica che salva milioni di vite ogni anno. Il problema dietro questo approccio sta proprio nel fatto che spesso manca il sangue. Poter produrre globuli rossi in laboratorio e su richiesta, in particolare relativi al sangue donatore universale (O+), potrebbe essere dunque importante per i casi gravi. Inoltre la produzione veloce e più facile potrebbe essere utile per la ricerca su alcune malattie, tra cui la malaria.
Uno dei problemi maggiori della produzione di globuli rossi sta nella creazione non voluta di sottoprodotti non desiderati. Per questo esistono i metodi di purificazione, che però sono costosi e non applicabili su larga scala. Il progetto del laboratorio SMART tende a sopperire proprio a ciò, rendendo l’intero processo di purificazione più facile e più economico, e quindi la stessa produzione di globuli rossi più efficiente.
Lo stesso metodo è descritto in uno studio pubblicato su Lab on a Chip ed è differente da quello tradizionale,m che di solito richiede 23 giorni perché le cellule crescano in laboratorio, comincino a espandersi e infine a maturare in globuli rossi, come spiega Kerwin Kwek, autore principale dello studio, il quale aggiunge: “Il nostro protocollo ottimizzato immagazzina le cellule coltivate in azoto liquido in quello che normalmente sarebbe il giorno 12 nel processo tipico e, su richiesta, scongela le cellule e produce i globuli rossi entro 11 giorni”.
I metodi di purificazione più diffusi esistenti, il Dean Flow Fractionation (DFF) e il Deterministic Lateral Displacement (DLD), sono stati modificati dai ricercatori per creare globuli rossi purificati che mantengono la loro funzionalità cellulare. Il tutto in un tempo di elaborazione molto più rapido, che non richiede, tra l’altro, tecnici qualificati per realizzare l’intera procedura.
Redazione Nurse Times
NotizieScientifiche.it

Lascia un commento